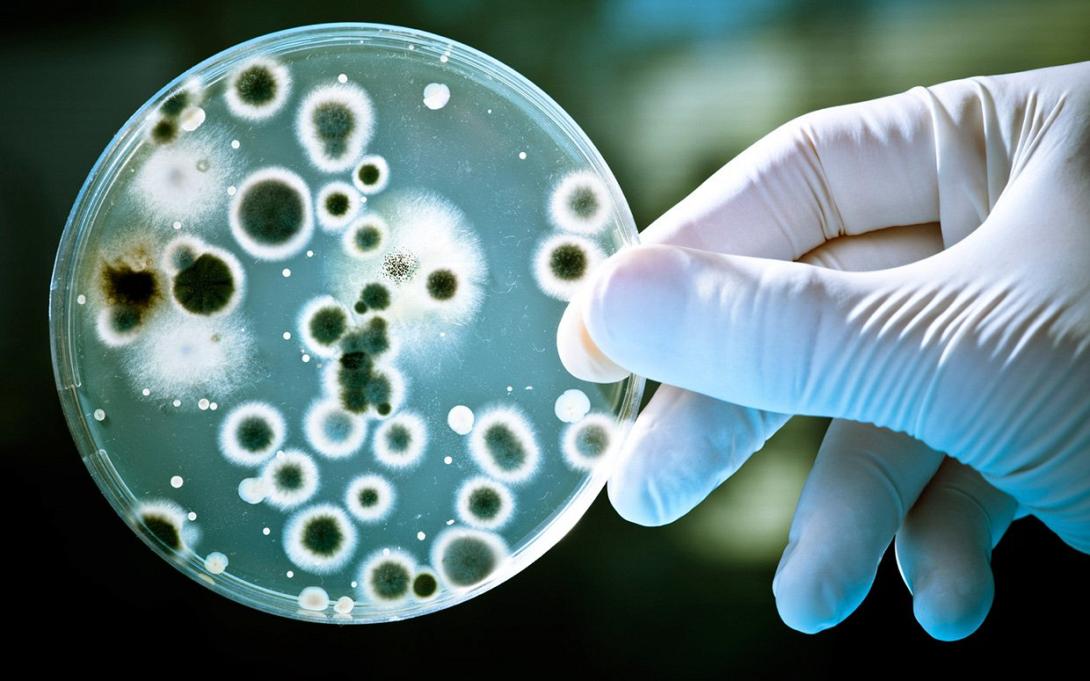
βακτήρια,τριβλίο

Τα πολυπληθή βακτήρια που ζουν στο έντερο φαίνεται να παίζουν σημαντικό ρόλο στο κατά πόσο θα συρρικνωθούν οι όγκοι ενός ασθενούς μετά από μια αντικαρκινική ανοσοθεραπεία, σύμφωνα με δύο νέες επιστημονικές έρευνες, μια γαλλική και μια αμερικανική.
Οι δύο έρευνες, που δημοσιεύθηκαν στο περιοδικό, αναδεικνύουν τη σημασία του μικροβιώματος, του «οικοσυστήματος» των τρισεκατομμυρίων βακτηρίων και άλλων μικροοργανισμών που υπάρχουν μέσα στον άνθρωπο. Οι μελέτες έγιναν σε καρκινοπαθείς που έκαναν ανοσοθεραπεία (με αναστολείς PD-1) για να ενισχύσουν την άμυνα του οργανισμού τους, ώστε να καταπολεμήσει τους όγκους.
Η μία έρευνα, στο Αντικαρκινικό Κέντρο Γκουστάβ Ρουσί στην πόλη Βιλζουίφ της Γαλλίας, με επικεφαλής την ανοσολόγο Λοράνς Ζιτβοζέλ, έγινε σε 249 ασθενείς με καρκίνο των πνευμόνων και των νεφρών. Η μελέτη διαπίστωσε ότι όσοι ασθενείς είχαν πάρει αντιβιοτικά για λοιμώξεις λίγο πριν ή λίγο μετά την έναρξη της αντικαρκινικής θεραπείας, ήταν πιθανότερο να εμφανίσουν μεγαλύτερους όγκους. Η ανοσοθεραπεία ήταν λιγότερο αποτελεσματική στην περίπτωσή τους, επειδή η μικροβιακή κοινότητά τους είχε αλλοιωθεί εξαιτίας των αντιβιώσεων.
Από την άλλη, ένα συγκεκριμένο είδος βακτηρίων (Akkermansia muciniphila) φάνηκε να βοηθά ιδιαίτερα την αντικαρκινική θεραπεία. Οι ερευνητές εκτιμούν ότι απλώς η αποφυγή της λήψης αντιβίωσης στη διάρκεια της αντικαρκινικής ανοσοθεραπείας μπορεί να αυξήσει από 25% σε 40% το ποσοστό των ασθενών που ανταποκρίνονται θετικά στην θεραπεία με αναστολείς PD-1.
Η δεύτερη έρευνα, στο Αντικαρκινικό Κέντρο Άντερσον του Πανεπιστημίου του Τέξας, με επικεφαλής την Τζένιφερ Γουάργκο, έγινε σε 112 ασθενείς με προχωρημένο μελάνωμα του δέρματος.
Διαπιστώθηκε ότι όσοι ανταποκρίνονταν καλύτερα στην ανοσοθεραπεία, ήσαν αυτοί που είχαν πιο πλούσιο μικροβίωμα με μεγαλύτερη ποικιλία βακτηρίων. Ιδιαίτερα επωφελή ήσαν τα υψηλά επίπεδα ορισμένων βακτηρίων (Faecalibacterium και Clostridiales), ενώ επιβλαβή ήσαν κάποια άλλα (Bacteroidales).
Η ανάλυση δειγμάτων ιστών έδειξε ότι υπήρχαν περισσότερα ανοσοκύτταρα που καταστρέφουν τα καρκινικά κύτταρα, στους όγκους των ασθενών με τα περισσότερα «καλά» βακτήρια. Στη συνέχεια, πειράματα σε πειραματόζωα έδειξαν ότι η μεταφορά «καλών» βακτηρίων μπορούσε να επιβραδύνει την ανάπτυξη των όγκων στα ζώα που αρχικά είχαν περισσότερα «κακά» βακτήρια - κάτι που θα ήταν ίσως δυνατό να επαναληφθεί στους ανθρώπους.
Θα ακολουθήσουν έτσι και άλλες κλινικές δοκιμές για να μελετηθεί ο ρόλος και η δυνατότητα αξιοποίησης των βακτηρίων στη μάχη κατά του καρκίνου. Στόχος είναι να διερευνηθεί κατά πόσο η δημιουργία ενός πιο ευνοϊκού μικροβιώματος στους καρκινοπαθείς θα τους βοηθήσει να ανταποκριθούν καλύτερα στα νέα αντικαρκινικά φάρμακα, όπως το Keytruda (pembrolizumab) και το Opdivo (nivolumab),«απελευθερώνοντας» το ανοσοποιητικό σύστημα να επιτεθεί στους όγκους.
ΑΜΠΕ